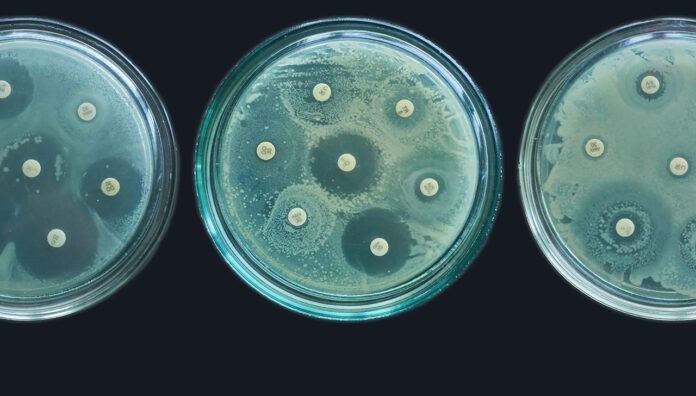
GettyImages-1338060628_WEB

A blistering opening plenary session at the FIP Congress in September has challenged policymakers and health professionals alike to act to slow the advance of antimicrobial resistance (AMR).
Mr Michele Cecchini, Head of Public Health, Organisation for Economic Co-operation and Development (OECD), worked through startling data showing the cost of AMR globally – in dollars, and in years of life lost.
The high price of insufficient action on AMR
The OECD has crunched the numbers, and the statistics are startling.
AMR is currently shortening life expectancy by an average of 1.8 years globally – 1.7 years for people in high-income countries, or 2.5 years for people in low-income countries.
This is represented in 79,000 people dying due to resistant infections across 34 OECD, European Union and European Economic Area counties – corresponding to 2.4 times the number of deaths due to tuberculosis, influenza and HIV/AIDS combined in 2020.
The financial burden on the health system is similarly staggering, with global annual costs totalling $US 412 billion.
Once lost productivity and loss of income costs are added in, this cost balloons to $US 850 billion annually – about the same size of Poland’s economy.
Bold action is required
Modelling by the OECD has shown that meaningful action is achievable – albeit with a substantial price tag.
To reduce AMR-related deaths by 10%, six actions are required:
- All countries need to have national AMR action plans and 60% of countries commit a budget
- 90% of countries should meet WHO’s minimum infection prevention and control programs at a national level
- All countries need to report surveillance data on AMR and antimicrobial use
- Meaningful reduction in antimicrobial use is taken in agrifood systems
- Strengthened actions to prevent and address the discharge of antimicrobials into the environment
- Mechanisms to support research and development to address AMR should be promoted.
The cost of these initiatives globally is estimated to be $US 52 billion annually – equivalent to 0.5% of the global health budget.
‘The World Bank told us this is a rounding error [in the context of health spending]. This is not an amount of money which cannot be mobilised,’ Mr Cecchini said.
These sentiments were echoed by the Danish Minister for the Interior and Health Sophie Løhde.
‘To tackle [AMR], we need to work much closer together, and your role as pharmacists and life science professionals is key,’ said Minister Løhde at the first plenary session of the 2025 FIP world congress. ‘We need your expertise to develop new antimicrobials in the most prudent and effective manner, and to inform and educate our citizens when you meet them in pharmacies all over the world.’
The FIP Copenhagen Declaration on Antimicrobial Resistance, signed by 79 organisations – including The Pharmaceutical Society of Australia – took place on 1 September 2025.
The FIP Declaration outlines clear priorities to address AMR, including global partnership building, promoting vaccination and rational antimicrobial use, protecting medicine supply chains, and advancing evidence on stewardship and outcomes.

Rebecca Davies[/caption]

Professor Clare Collins[/caption]
Associate Professor Trevor Steward[/caption]



Amy Gibson MPS[/caption]